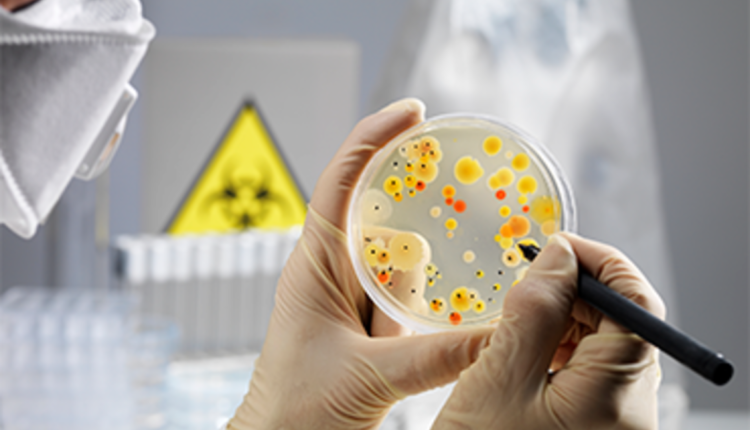
أفضل 3 مواقع ميكروبيولوجي لتعليم الأحياء الدقيقة مجانًا!

تحدثنا من قبل عن قنوات عربية لتعلم علم الأحياء الدقيقة التي تمتاز بأنها متوفرة مجانًا من خلال منصة اليوتيوب، واليوم سوف نستعرض لك مجموعة من أفضل 5 مواقع ميكروبيولوجي لذلك تعتبر هذه المصادر بمثابة مساعدة لمن يدرس علم الميكروبيولوجي في إحدى الجامعات العربية والعالمية حيث تمتاز بأنها تدعم اللغة الإنجليزية وتناسب كافة الفرق والسنوات الدراسية المختلفة.
موقع Microbe Online

يعتبر هذا الموقع من أفضل المواقع المتخصصة في تعليم الميكروبيولوجي من الصفر حتى الاحتراف حيث يضم مجموعة من الفروع التي يهتم بها ومنها:
- Bacteriology = علم البكتيريا.
- Immunology = علم المناعة.
- Parasitology = علم الطفيليات.
- Mycology = علم الفطريات.
- Virology = علم الفيروسات.
- Molecular Biology = علم الأحياء الجزيئية.
فمثلًا في قسم Parasitology، ستجد بداخلها مجموعة من الدروس التي تختص في تسهيل وتبسيط علم الطفيليات لمن يريد لذلك يحتوي على بعض الشروحات التالية:
- Naegleria fowleri: Characteristics, Pathogenesis and Lab Diagnosis.
- Ascaris lumbricoides: Life cycle, Pathogenesis and Lab Diagnosis.
- Antigens in disease diagnosis.
- Sabin-Feldman dye test: Principle and Limitations.
- Entamoeba histolytica: Life Cycle, Diseases, Lab Diagnosis.
- Direct Saline/ Iodine Wet Mount for Diagnosis of Intestinal Parasites.
- Fecal Occult Blood Test (FOBT): Procedure, Results.
وفي قسم Virology، تستطيع من خلال هذا الجزء فهم علم الفيروسات ليكون مناسب لطلبة علوم على وجه الخصوص ومن الدروس الموجودة بداخله ما يلي
- Bacteriophage: Structure, Replication, Uses.
- Antigen Testing for COVID-19: Principle, Procedure, Results.
- Collection and Transport of Nasopharyngeal Swab.
- Embryonated Egg Cultures for Viruses.
- Japanese Encephalitis (JE) Virus: Life Cycle, Pathogenesis, Diagnosis.
- Prevention of Ebola Virus Disease.
موقع Microbiology Info

يعتبر هذا المصدر من أشهر مواقع ميكروبيولوجي التي تساعد المبتدئين والمتخصصين في تعلم وقراءة المقالات التعليمية التي تختص في تبسيط مبادئ علم الأحياء الدقيقة لمن يشاء، فهو يحتوي على الكثير من المواضيع الرئيسية وهي
- Bacterial Identification = التعرف على البكتيريا.
- Bacteriology = علم البكتيريا.
- Basic Microbiology = أساسيات الميكروبيولوجي.
- Biochemical Test = اختبارات الكيمياء الحيوية.
- Biochemical Test of Bacteria = اختبار البكتيريا من حيث الكيمياء الحيوية.
- Biochemistry = البايوكمستري.
- Biology = الأحياء.
- Cell Biology = بيولوجيا الخلية.
- Culture Media.
- Differences Between = الفروق بين.
- Diseases = الأمراض.
- Haematology = علم الدم.
- Immunology = علم المناعة.
- Laboratory = المعمل.
- Mycology = علم الفطريات.
- Parasitology = علم الطفيليات.
- Staining Techniques.
- Virology = علم الفيروسات.
ومن أمثلة الموضوعات التي سوف تجدها في قسم Cell Biology ليصبح من أشهر مواقع تعليم الأحياء المجانية ما يلي
- Mode of Action of Antifungal Drugs.
- Difference between Serum and Plasma.
- Techniques of Virus Cultivation.
- Differences between DNA and RNA.
- Different Size, Shape and Arrangement of Bacterial Cells.
وفي قسم Diseases، ستجد بعض الموضوعات المرتبطة بالأمراض مثل
- Differences Between Chickenpox and Smallpox.
- Scrub Typhus- Etiology, Epidemiology, Symptoms, Pathogenesis, Diagnosis and Treatment.
- Difference Between Meningitis and Encephalitis.
موقع Microbe Notes

يوفر لك هذا الموقع مجموعة من الملاحظات التي تساعدك على فهم علم الأحياء الدقيقة مما يجعله مناسب لمن يبحث عن مواقع ميكروبيولوجي، كما يضم مجموعة متنوعة أخرى من المصطلحات المرتبطة به التي تمتاز بأنها مرتبة ترتيبًا أبجديًا أي من A إلى Z مثل
- AB toxins.
- ABO blood group system.
- Abscess.
- Acid.
- Acidophile.
- Antibody.
- Activation-induced cytidine deaminase (AID).
- Water molds.
- Western blot.
- Whitlow.
كما يمتاز بأنه يوفر لك مربع البحث لتستطيع من خلاله البحث عن أي مصطلح أو قسم تريده لكي تتمكن من فهم الفروع والعلوم المرتبطة بالميكروبيولوجي بكل سهولة.
موقع Learn Microbiology

يُعد موقع Learn Microbiology من أشهر المواقع التعليمية المتخصصة في علم الميكروبيولوجي، حيث يقدّم محتوى علميًا مبسّطًا ومُنظمًا يساعد المبتدئين والمتخصصين على تعلّم وفهم أساسيات علم الأحياء الدقيقة بطريقة سهلة وواضحة، مع الاعتماد على الشرح النظري والأمثلة التطبيقية.
ويتميّز الموقع بأنه لا يقتصر فقط على شرح المفاهيم العلمية، بل يجمع بين:
-
قسم تعليمي لشرح الميكروبيولوجي
-
وقسم آخر لاختبار مستواك العلمي فيما تعلّمته
- قسم Learn Microbiology
يحتوي الموقع على عدد كبير من الأقسام الرئيسية التي تغطي أغلب فروع علم الأحياء الدقيقة والعلوم الطبية المرتبطة به، ومن أبرزها:
-
Bacterial Identification = التعرّف على البكتيريا
-
Bacteriology = علم البكتيريا
-
Basic Microbiology = أساسيات الميكروبيولوجي
-
Biochemical Test = اختبارات الكيمياء الحيوية
-
Biochemical Test of Bacteria = اختبارات البكتيريا من حيث الكيمياء الحيوية
-
Biochemistry = الكيمياء الحيوية
-
Biology = علم الأحياء
-
Cell Biology = بيولوجيا الخلية
-
Culture Media = أوساط الزراعة
-
Differences Between = الفروق بين المفاهيم العلمية
-
Diseases = الأمراض
-
Haematology = علم الدم
-
Immunology = علم المناعة
-
Laboratory = المعمل
-
Mycology = علم الفطريات
-
Parasitology = علم الطفيليات
-
Staining Techniques = تقنيات الصبغ
-
Virology = علم الفيروسات
ومن أمثلة الموضوعات الموجودة في قسم Cell Biology ما يلي
يضم قسم بيولوجيا الخلية (Cell Biology) مجموعة مميزة من الموضوعات التعليمية، من أبرزها:
-
Mode of Action of Antifungal Drugs
-
Difference between Serum and Plasma
-
Techniques of Virus Cultivation
-
Differences between DNA and RNA
-
Different Size, Shape and Arrangement of Bacterial Cells
وهو ما يجعل الموقع من أشهر مواقع تعليم الأحياء الدقيقة والميكروبيولوجي المجانية للطلاب والباحثين.
ومن أمثلة الموضوعات الموجودة في قسم Diseases ما يلي
كما يوفّر الموقع محتوى علميًا غنيًا في قسم الأمراض (Diseases)، ومن أمثلة الموضوعات التي ستجدها:
-
Differences Between Chickenpox and Smallpox
-
Scrub Typhus – Etiology, Epidemiology, Symptoms, Pathogenesis, Diagnosis and Treatment
-
Difference Between Meningitis and Encephalitis
- قسم Microbiology MCQs & Quizzes
إلى جانب المحتوى التعليمي، يضم موقع Learn Microbiology جزءًا مخصصًا لـ:
-
اختبار مستواك العلمي
-
مراجعة ما تعلّمته من خلال أسئلة واختبارات
-
تعزيز الفهم والتطبيق العملي للمعلومات
وهو ما يساعد الطالب أو المتعلم على تقييم تقدّمه ومعرفة نقاط القوة والضعف لديه في علم الميكروبيولوجي. بالإضافة إلى أنه يحتوي على أشهر أسئلة الانترفيو وإجاباتها المرتبطة بعلم الأحياء الدقيقة في قسم Microbiology Interview Questions & Answers وكذلك أيضًا عرض لأشهر الأبحاث الأخيرة المتعلقة بمجال الميكروبيولوجي في قسم Latest Research Topics In Microbiology.
موقع Microbiology and Immunology On-line

يُعد موقع Microbiology and Immunology On-line من المواقع التعليمية المتخصصة في علم الميكروبيولوجي وعلم المناعة، وهو مصدر علمي موثوق يقدم محتوى أكاديميًا منظمًا يساعد طلبة الطب والعلوم الصحية والمبتدئين على فهم المفاهيم الأساسية والمتقدمة في الأحياء الدقيقة والمناعة.
ويتميّز الموقع بأسلوبه التعليمي الواضح، حيث يجمع بين الشرح النظري المنهجي والمراجعة العلمية، مما يجعله مناسبًا للتعلّم الذاتي والدراسة الجامعية. فيحتوي هذا الموقع على محتوى تعليمي غني مقسم إلى وحدات وأقسام رئيسية، من أبرزها:
-
General Microbiology = الميكروبيولوجي العامة
-
Bacteriology = علم البكتيريا
-
Virology = علم الفيروسات
-
Mycology = علم الفطريات
-
Parasitology = علم الطفيليات
-
Immunology = علم المناعة
-
Host–Pathogen Interaction = تفاعل العائل مع الممرض
-
Pathogenesis = آلية إحداث المرض
-
Antimicrobial Agents = المضادات الميكروبية
ويُقدم المحتوى بأسلوب أكاديمي مبسّط، مع تسلسل منطقي يساعد القارئ على بناء قاعدة علمية قوية في الميكروبيولوجي والمناعة.
ويمتاز هذا الموقع أيضًا بأنه متوفر بأكثر من لغة ومنها:
- الإنجليزية
- الفارسية
- الإسبانية
- التركية
- الألبانية
- البرتغالية
- الفيتنامية
وفي النهاية، لقد تناولنا في هذا المقال مواقع ميكروبيولوجي لتعلم كل ما تحتاجه في علم الأحياء الدقيقة، ولا تنسى عزيزي القاريء أن تقوم بمتابعتنا أيضًا على منصات التواصل الاجتماعي: